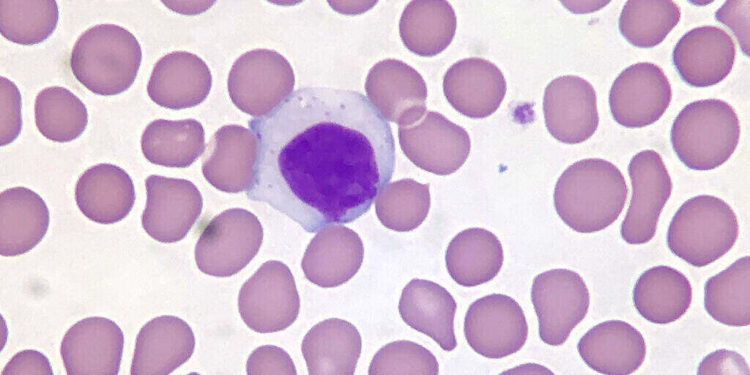
Cancer

Leukemia is a group of blood cancer cells rooting from the bone marrow due to a lack of normal blood cells creating an unusual amount of blood cells correlates increased risk of infections.
The cause of this is relatively unknown, a possibility is environmental and genetic factors, smoking, chemical exposure to benzene, ionizing radiation, past chemotherapy treatment, and down syndrome. Leukemia is the most typical type of cancer found in some children. However, more than 90 percent of all leukemia diagnoses are found in adults.
Scientists leading research in Barcelona, Spain have reached a breakthrough in reverting leukemia cancer cells back to normal. Contribution from the Department of Human Genetics and Biochemistry of Tel Aviv University’s Sackler Faculty of Medicine: Prof. Nitzan Kol, Gideon Rehavi, Chen Avrahami, and Sharon Moshitch-Moshkovitz all played pivotal roles in this development. The professors made headway by “remodeling the m6A RNA landscape in the conversion of acute lymphoblastic leukemia cells to macrophages.”
This discovery can be found in their now published high-impact journal on leukemia. In the detailed journal, the professors claim that by changing the chemical bonds of the leukemia cells, they can become normal cells no longer able to reproduce. The key is the Messenger RNA, it is the connection of a single-stranded molecule of RNA correspondent to genetic sequences of a gene that helps protein form.
Spanish participants included Alberto Bueno- Costa, a researcher part of a collective with Dr. Manel Estelle, who oversees Josep Carreras Leukemia Research Institute at the University of Barcelona. The process of cancer is slow and meticulous. Healthy cells turn into volatile cells with very opposing attributes. They divide rapidly and recklessly with research discovering dozens of molecular modifications connected directly to changes from healthy to tumor tissue.
Through decades of research cures for cancer seemed nearly impossible, a far-fetched dream weighed on the shoulders of scholars. Scientists reaching a breakthrough may be long overdue but here nonetheless. They have become more informed on the reversal of cancer cells, changing their physiological structure into a noncancerous one and capitalizing on the finding.

The team highlighted that human tumors are capable of changing their appearance to avoid the effects of medication against the tumor. An example of this manipulation in appearance is lymphoid lineages morphing into myeloid strains to “escape treatment.”
With further investigation, the team studied the function of the molecular routes for cellular transmutation. They used a vitro model for the study where they forced leukemia cells to transform into harmless immune cells called macrophages.
Through experimentation, results showed that the reversal of volatile cells into macrophages creates an alteration in the chemical mutation occurring in their messenger RNA. This directly affected the distribution of an “epigenetic mark named methylated adenine.” the team says.
The goal of the team is for the preclinical drugs resulting from this research to be used in the fight against cancer. Adopting these findings and utilizing the science to mitigate the spread of leukemia and lymphoma could be “useful in cancer therapies,” Esteller said.
In Leukemia, two adjacent chemical bonds form proteins that create cancer cells. By modifying that angle formed between the two bonds, the bonds of the molecules will become unstable and fail to create the leukemias exclusive protein, therefore, favoring the opposing macrophages.
The future is bright, first, it was the COVID-19 vaccine, then it was pills to help terminate diabetes, and now science has found a way to possibly eliminate leukemia and lymphoma. Half a million patients around the world receive an annual diagnosis of blood malignancies. The research is promising and begets more investigation and testing to fight against leukemia. The process is long but productive, cancer beware.
Written by Mikal Eggleston
Source:
National Cancer Institute: Macrophage
FrontiersIn.org: Biomaterials/ Vitro Model
National Human Genome Research Institute: MESSENGER RNA (MRNA)
GENOME.GOV: MESSENGER RNA (MRNA)
Featured Image Courtesy of Ed Uthman’s Flickr Page – Creative Commons License
Inset Image Courtesy of Ed Uthman’s Flickr Page – Creative Commons License